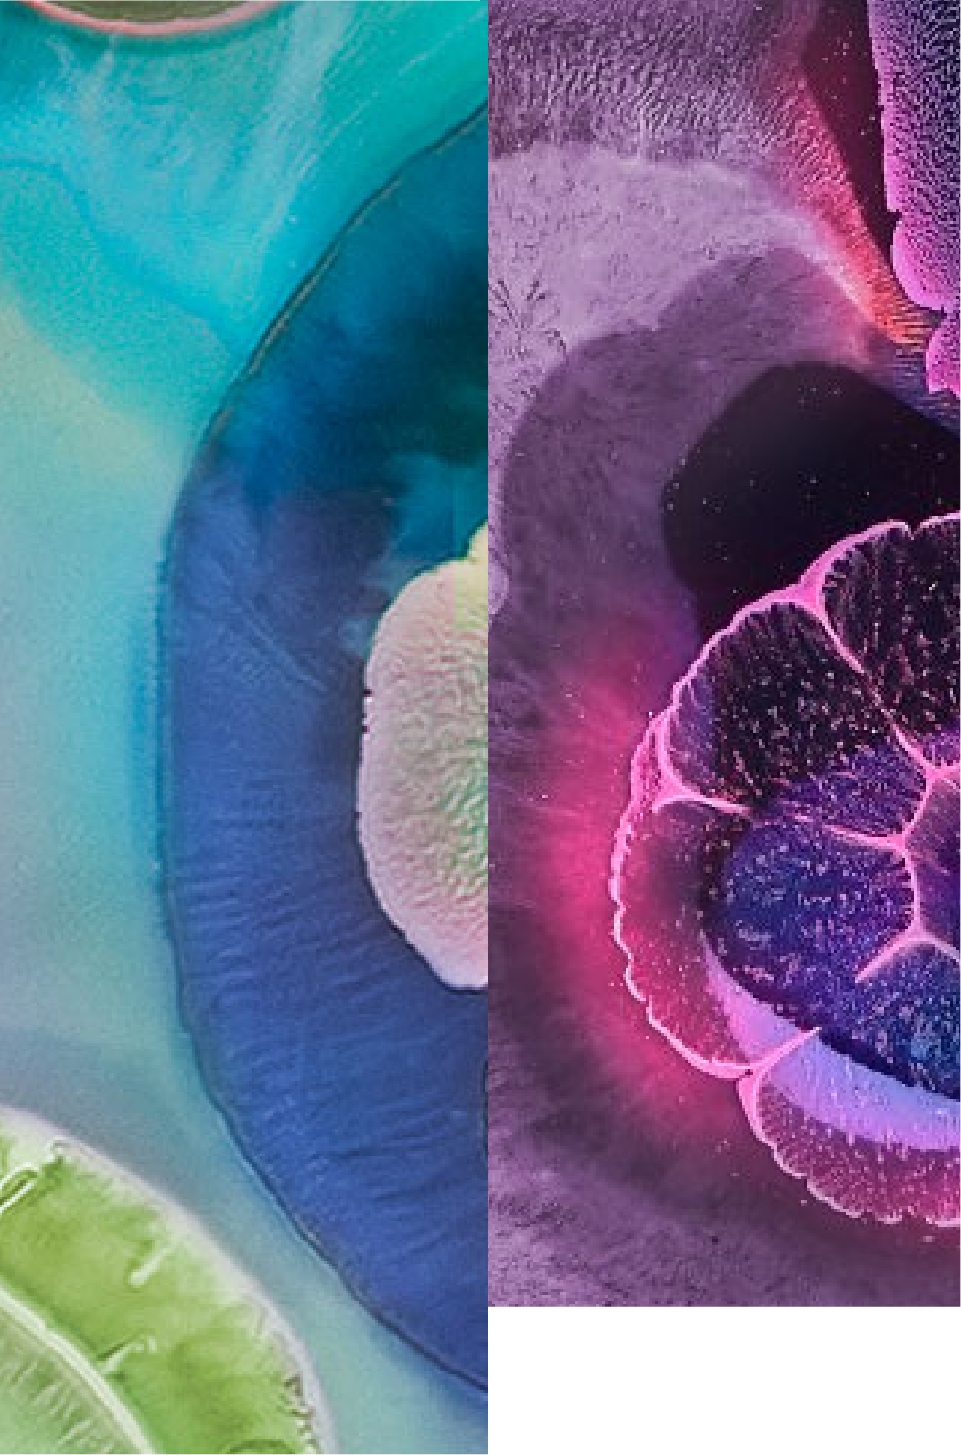
Dual Strain 35624® and 1714

Clinically shown to improve the ability to cope with stress and reduce anxiety
Lactobacillus paracasei L. CASEI 431®
- Lactobacillus paracasei L. CASEI 431®, an extensively studied bacteria strain which is able to survive the journey through the gastrointestinal tract 1.
- Lactobacillus paracasei, L. CASEI 431® has been shown to support immune health. There is evidence from human trials that this strain may beneficially modulate the immune system and may help to reduce the duration and severity of respiratory infections 2, 3, 4, 5.
Learn More in the Resource Centre
Other Strains
Resource Centre